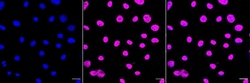
Invitrogen HDAC1 Recombinant Rabbit Monoclonal Antibody (23GB4785) 20 &mu;L | Buy Online | Invitrogen&trade; | Fisher Scientific

missing translation for 'onlineSavingsMsg'
Learn More
Learn More
Invitrogen™ HDAC1 Recombinant Rabbit Monoclonal Antibody (23GB4785)
Description
HDAC1 Recombinant Monoclonal Antibody for Flow, ICC/IF, Western Blot
Histone acetylation and deacetylation, catalyzed by multisubunit complexes, play a key role in the regulation of eukaryotic gene expression. HDAC1 belongs to the histone deacetylase/acuc/apha family and is a component of the histone deacetylase complex. It also interacts with retinoblastoma tumor-suppressor protein and this complex is a key element in the control of cell proliferation and differentiation. Together with metastasis-associated protein-2, HDAC1 deacetylates p53 and modulates its effect on cell growth and apoptosis.
Specifications
Specifications
| Antigen | HDAC1 |
| Applications | Flow Cytometry, Western Blot, Immunocytochemistry |
| Classification | Recombinant Monoclonal |
| Clone | 23GB4785 |
| Concentration | 0.4 mg/mL |
| Conjugate | Unconjugated |
| Formulation | PBS with 50% glycerol and 0.02% sodium azide; pH 7.4 |
| Gene | HDAC1 |
| Gene Accession No. | O09106, Q13547, Q4QQW4 |
| Gene Alias | DKFZp686H12203; GON-10; HD1; Hdac1; Hdac1-ps; Histone deacetylase 1; histone deacetylase 1-like protein; MommeD5; reduced potassium dependency, yeast homolog-like 1; RP4-811H24.2; RPD3; RPD3L1 |
| Show More |